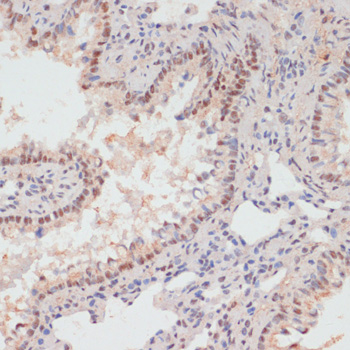
Immunohistochemistry - Phospho-PEA15-S104 pAb
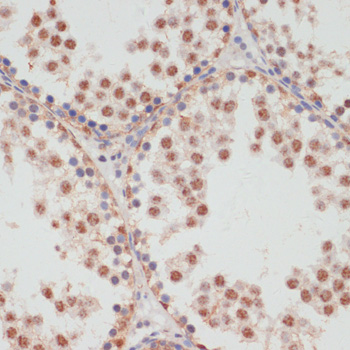
Immunohistochemistry - Phospho-PEA15-S104 pAb
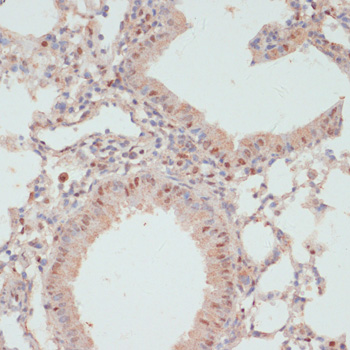
Immunohistochemistry - Phospho-PEA15-S104 pAb

-
Product Name
Phospho-PEA15-S104 pAb
- Documents
-
Description
Polyclonal antibody to Phospho-PEA15-S104
-
Tested applications
WB, IHC
-
Species reactivity
Human, Mouse, Rat
-
Alternative names
PEA15 antibody; HMAT1 antibody; HUMMAT1H antibody; MAT1 antibody; MAT1H antibody; PEA-15 antibody; PED antibody; astrocytic phosphoprotein PEA-15 antibody
-
Isotype
Rabbit IgG
-
Preparation
Antigen: A synthetic phosphorylated peptide around S104 of human PEA15 (NP_003759.1).
-
Clonality
Polyclonal
-
Formulation
PBS with 0.02% sodium azide, 50% glycerol, pH7.3.
-
Storage instructions
Store at -20℃. Avoid freeze / thaw cycles.
-
Applications
WB 1:500 - 1:2000
IHC 1:50 - 1:100 -
Validations
Immunohistochemistry - Phospho-PEA15-S104 pAb
Immunohistochemistry of paraffin-embedded rat lung using Phospho-PEA15-S104 antibody at dilution of 1:100 (40x lens).
Immunohistochemistry - Phospho-PEA15-S104 pAb
Immunohistochemistry of paraffin-embedded rat testis using Phospho-PEA15-S104 antibody at dilution of 1:100 (40x lens).

Immunohistochemistry - Phospho-PEA15-S104 pAb
Immunohistochemistry of paraffin-embedded rat brain using Phospho-PEA15-S104 antibody at dilution of 1:100 (40x lens).

Immunohistochemistry - Phospho-PEA15-S104 pAb
Immunohistochemistry of paraffin-embedded human tonsil using Phospho-PEA15-S104 antibody at dilution of 1:100 (40x lens).

Immunohistochemistry - Phospho-PEA15-S104 pAb
Immunohistochemistry of paraffin-embedded human lung cancer using Phospho-PEA15-S104 antibody at dilution of 1:100 (40x lens).

Immunohistochemistry - Phospho-PEA15-S104 pAb
Immunohistochemistry of paraffin-embedded human appendix using Phospho-PEA15-S104 antibody at dilution of 1:100 (40x lens).

Immunohistochemistry - Phospho-PEA15-S104 pAb
Immunohistochemistry of paraffin-embedded human gastric cancer using Phospho-PEA15-S104 antibody at dilution of 1:100 (40x lens).
Immunohistochemistry - Phospho-PEA15-S104 pAb
Immunohistochemistry of paraffin-embedded mouse lung using Phospho-PEA15-S104 antibody at dilution of 1:100 (40x lens).

Immunohistochemistry - Phospho-PEA15-S104 pAb
Immunohistochemistry of paraffin-embedded mouse testis using Phospho-PEA15-S104 antibody at dilution of 1:100 (40x lens).

Immunohistochemistry - Phospho-PEA15-S104 pAb
Immunohistochemistry of paraffin-embedded mouse brain using Phospho-PEA15-S104 antibody at dilution of 1:100 (40x lens).
-
Background
Blocks Ras-mediated inhibition of integrin activation and modulates the ERK MAP kinase cascade. Inhibits RPS6KA3 activities by retaining it in the cytoplasm (By similarity). Inhibits both TNFRSF6- and TNFRSF1A-mediated CASP8 activity and apoptosis. Regulates glucose transport by controlling both the content of SLC2A1 glucose transporters on the plasma membrane and the insulin-dependent trafficking of SLC2A4 from the cell interior to the surface.
Related Products / Services
Please note: All products are "FOR RESEARCH USE ONLY AND ARE NOT INTENDED FOR DIAGNOSTIC OR THERAPEUTIC USE"
